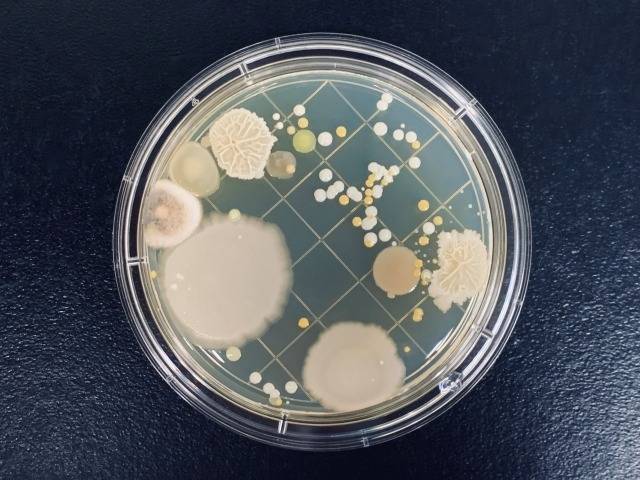
目に見えるカビは実は“コロニー”?!MIST工法®カビバスターズ本部が解説

東京都足立区でのカビ取りは専門調査が重要|再発を防ぐために今知っておきたいカビ対策の基礎知識
2026/02/14
東京都足立区でのカビ取りは専門調査が重要|再発を防ぐために今知っておきたいカビ対策の基礎知識
見えないカビの原因を徹底調査|真菌検査・含水率測定・負圧検査で安心できる住環境へ
東京都足立区にお住まいの皆さま、こんにちは。
近年、足立区を含む東京都内では「何度掃除してもカビが再発する」「見えない場所からカビ臭がする」「健康への影響が心配」といった、深刻なカビトラブルのご相談が増えています。現代の住宅は気密性・断熱性が高く、一見快適に思える反面、湿気がこもりやすく、カビにとって非常に繁殖しやすい環境が整ってしまうケースも少なくありません。
多くの方が市販の洗剤や自己流の掃除で対応しようとしますが、実はそれだけでは根本解決にならないことがほとんどです。なぜなら、カビは目に見える表面だけでなく、壁の内部、天井裏、床下など、普段確認できない場所で静かに広がっている場合が多いからです。原因を正確に突き止めずに対処をすると、一時的にきれいになっても再発するリスクが非常に高くなります。
MIST工法®カビバスターズでは、日本全国のカビトラブルに対応しており、足立区のような都市部特有の住宅事情も踏まえたカビ対策のご相談を多くいただいています。特に重要なのが、**「なぜその場所にカビが発生したのか」**という原因の特定です。そのためには、専門的な調査や検査が欠かせません。
また、カビ問題が心配な方には、一般社団法人微生物対策協会と連携した真菌(カビ菌)検査を強くおすすめしています。目に見えないカビ菌の種類や量を把握することで、室内環境のリスクを客観的に判断できるようになります。健康的で安心できる住環境を守るためにも、自己判断ではなく、専門的な視点を取り入れることが大切です。
目次
東京都足立区でカビが発生しやすい本当の理由とは?現代住宅に潜む見えないリスク
気候・建物構造・生活習慣が重なり合う足立区特有のカビ発生メカニズムをわかりやすく解説
東京都足立区でカビに関するご相談が増えている背景には、いくつかの明確な理由があります。
足立区は都内でも住宅が密集しているエリアが多く、戸建て・集合住宅ともに風通しが悪くなりやすい立地条件が見られます。さらに、荒川や隅田川といった河川に近い地域も多く、年間を通して空気中の湿度が高くなりやすい傾向があります。この「湿度の高さ」は、カビにとって非常に好都合な環境です。
加えて、近年の住宅は省エネ性能を高めるため、気密性・断熱性が向上しています。一見すると快適で良い住環境に思えますが、実は湿気が外へ逃げにくく、室内に滞留しやすいという弱点も抱えています。換気が十分に行われていなかったり、目に見えない場所で結露が発生していたりすると、壁の内部や天井裏、床下といった確認しづらい部分でカビが静かに繁殖してしまうのです。
特に注意が必要なのは、「表面にはカビが見えていないから大丈夫」と思い込んでしまうケースです。実際には、カビは建材の内部や空気中にも存在しており、気づかないうちに室内環境へ影響を及ぼしていることがあります。カビ臭さや体調不良をきっかけに調査を行った結果、壁の中で広範囲にカビが確認されることも珍しくありません。
このような背景から、東京都足立区でのカビ問題は原因を正しく見極めることが何より重要です。なぜその場所に湿気が溜まり、なぜカビが発生したのかを調査せずに対処してしまうと、再発の可能性が非常に高くなります。
手に負えないカビトラブルや、健康への影響が心配な場合は、全国のカビ問題に対応している**MIST工法®カビバスターズ**へ相談することで、根本原因を見据えた判断につながります。
見えない場所に潜むカビの危険性|壁の中・天井裏・床下で進行するカビ被害
目に見えないからこそ怖いカビ問題|気づいた時には広範囲に広がっている可能性も
カビというと、壁紙の表面や浴室など、目に見える場所に発生するものというイメージを持たれている方が多いのではないでしょうか。しかし、東京都足立区で実際に多く見られるのは、見えない場所で静かに進行しているカビ被害です。これこそが、カビ問題を深刻化させる大きな原因のひとつです。
特に注意が必要なのが、壁の内部、天井裏、床下といった普段の生活では確認できない空間です。これらの場所は、湿気がこもりやすく、空気の流れも悪いため、カビが発生・繁殖しやすい条件が揃っています。外から見ただけでは異常が分からず、「カビ臭い」「空気が重い」「家族の体調がすぐれない」といった違和感から、はじめて問題に気づくケースも少なくありません。
見えない場所で発生したカビは、やがて胞子となって空気中に広がる可能性があります。これにより、室内全体の空気環境が悪化し、アレルギー症状や体調不良につながる恐れも指摘されています。特に小さなお子さまや高齢の方がいるご家庭では、早めの対応が重要です。
また、表面だけを掃除して一時的にカビが消えたとしても、内部に原因が残っていれば再発を繰り返す可能性が高くなります。現代の住宅は構造が複雑で、湿気の逃げ道が限られているため、原因を追究せずに対処することは非常にリスクが高いと言えるでしょう。
こうした見えないカビのリスクに対しては、専門的な視点での調査が欠かせません。MIST工法®カビバスターズでは、壁の内部状態を確認するためにファイバースコープを用いた調査を行い、目視できない部分の状況を把握しています。また、建材の状態を確認する含水率検査や、室内の空気の流れを調べる風量計による負圧検査などを通じて、カビが発生した根本的な原因を探ります。
「見えないから大丈夫」ではなく、「見えないからこそ調べる」。
これが、東京都足立区でカビ問題を繰り返さないために欠かせない考え方です。
次章では、再発防止のカギとなる専門調査の重要性について、さらに詳しく解説していきます。
カビ再発を防ぐために欠かせない専門調査|原因を突き止めない対策は意味がない
ファイバースコープ・含水率検査・負圧検査で見える化するカビ発生の本当の原因
東京都足立区でカビトラブルが長期化・再発しやすい理由のひとつに、**「原因を調べないまま対処してしまう」**という点が挙げられます。カビは結果であって、原因ではありません。表面に現れたカビだけを除去しても、湿気の供給源や空気の流れといった根本的な問題が解決されていなければ、時間の経過とともに再び発生してしまいます。
そこで重要になるのが、専門的な調査による原因の見える化です。
まず、壁の中や天井裏など、普段は確認できない場所については、ファイバースコープを用いた内部調査を行うことで、カビの有無や結露跡、劣化の状態などを直接確認することが可能になります。これにより、「どこで」「どのように」問題が起きているのかを把握できます。
次に欠かせないのが、建材の含水率検査です。木材や石膏ボードなどの建材は、水分を含みすぎるとカビが非常に発生しやすくなります。見た目が乾いているように見えても、内部に水分を含んでいるケースは少なくありません。数値として含水率を確認することで、カビが発生しやすい危険な状態かどうかを客観的に判断できます。
さらに、現代住宅特有の問題として注目されているのが、室内の空気バランスです。風量計を使用した負圧検査では、室内が必要以上に負圧状態になっていないかを確認します。負圧が強すぎると、壁内部や床下から湿気やカビ胞子を室内へ引き込んでしまう可能性があり、知らないうちに空気環境を悪化させていることもあります。
これらの調査を組み合わせることで、
「なぜその場所にカビが発生したのか」
「再発のリスクはどこにあるのか」
を総合的に判断することができます。
カビ問題は、感覚や経験だけで判断すると見落としが起こりやすい分野です。だからこそ、数値・映像・検査結果に基づいた専門的な調査が不可欠なのです。
次章では、カビ問題が心配な方にぜひ知っていただきたい「真菌(カビ菌)検査」の重要性について、わかりやすく解説していきます。
目に見えない不安を数値で把握する真菌検査|カビ菌の存在を正しく知ることが第一歩
空気中や室内に潜むカビ菌を可視化|健康と住環境を守るための重要な検査とは
東京都足立区でカビの相談を受ける中で、「見た目にはカビがないのに不安」「掃除はしているのに体調がすぐれない」といった声を多く耳にします。こうしたケースで重要になるのが、真菌(カビ菌)検査です。カビは必ずしも目に見える形で存在しているとは限らず、空気中や建材内部にカビ菌として潜んでいる場合があります。
真菌検査とは、室内の空気や環境中にどのような種類のカビ菌が、どの程度存在しているのかを調べる検査です。これにより、「本当にカビ菌が多い環境なのか」「健康への影響が懸念される状態なのか」を感覚ではなく客観的なデータとして把握することが可能になります。特に、カビ臭がする、アレルギー症状が出やすい、原因不明の不調が続いているといった場合には、非常に有効な判断材料となります。
MIST工法®カビバスターズでは、**一般社団法人微生物対策協会**と連携し、専門的な視点に基づいた真菌検査の重要性を重視しています。カビと一口に言っても、その種類や性質はさまざまで、環境によってリスクの度合いも異なります。だからこそ、「とりあえずカビ対策をする」のではなく、まずは現状を正しく知ることが大切なのです。
また、真菌検査は「すでにカビが発生している家」だけのものではありません。
✔ 新築・中古住宅を購入したばかりで不安な方
✔ 小さなお子さまや高齢のご家族がいるご家庭
✔ カビ問題を未然に防ぎたい方
こうした方々にも、予防の観点から強くおすすめできる検査です。
カビ問題は、放置すると住環境の快適性だけでなく、健康面にも影響を及ぼす可能性があります。見えないからこそ後回しにせず、真菌検査によって現状を把握し、必要な対策を考えることが、安心できる暮らしへの近道と言えるでしょう。
次章では、**調査結果を踏まえて「なぜ原因改善が重要なのか」**について、現代住宅の特性とあわせて解説していきます。
カビは「結果」にすぎない|原因改善を行わなければ再発する現代住宅の落とし穴
結露・湿気・空気の流れを無視した対策がカビ再発を招く理由をやさしく解説
カビが発生すると、多くの方は「どうやってカビを取るか」に意識が向きがちです。しかし、本当に重要なのはその一歩手前、なぜカビが発生したのかという原因に目を向けることです。カビはあくまで結果であり、原因が残ったままでは、どれほど対処しても再発する可能性が高くなります。
特に東京都足立区を含む都市部の住宅では、結露・湿気・換気不足といった要素が複雑に絡み合っています。冬場の室内外の温度差による結露、梅雨や夏場の高湿度、そして高気密住宅による空気の滞留。これらが重なることで、壁の内部や天井裏、床下といった見えない場所に湿気が溜まり、カビが発生しやすい環境がつくられてしまうのです。
また、現代の建物では空気の流れが計画的に設計されている一方で、換気設備の使い方や生活習慣によっては、設計通りに機能していないケースも少なくありません。負圧状態が強くなりすぎると、壁内部や床下から湿気やカビ菌を室内に引き込んでしまうこともあります。こうした状態に気づかず生活を続けていると、「原因がわからないままカビが繰り返し発生する」という悪循環に陥ってしまいます。
原因改善が重要なのは、カビの再発を防ぐためだけではありません。室内環境が整うことで、空気の質が改善され、住まいの快適性や安心感も大きく向上します。逆に、原因を放置したままでは、表面上きれいに見えても、内部では問題が進行している可能性があります。
だからこそ、カビ対策では調査・検査によって原因を明確にし、改善につなげる視点が欠かせません。
次章では、東京都足立区でカビ問題に悩んだとき、どのようなタイミングで専門家に相談すべきかについて、わかりやすく解説していきます。
手に負えないカビトラブルは専門家へ|東京都足立区で相談すべきタイミングとは
自己判断がリスクを高める前に|カビ問題を悪化させないための正しい相談の考え方
カビが発生したとき、「もう少し様子を見よう」「自分で何とかできそう」と判断してしまう方は少なくありません。しかし、東京都足立区で実際に起きている多くのケースを見ると、その判断が結果的に被害を大きくしてしまうこともあります。特に、何度も同じ場所にカビが出る、カビ臭が消えない、体調への影響が気になるといった場合は、注意が必要です。
カビ問題が難しいのは、原因がひとつとは限らない点にあります。湿気、結露、空気の流れ、建材の状態、生活環境などが複雑に絡み合い、表面からは判断できない場所で問題が進行していることも少なくありません。そのため、自己流の対処を繰り返すほど、原因の特定が遅れ、再発リスクが高まる傾向があります。
次のような状況に心当たりがある場合は、早めに専門家へ相談することをおすすめします。
・掃除しても短期間でカビが再発する
・壁や天井にシミや変色が出てきた
・室内がカビ臭く感じる
・家族の体調やアレルギーが気になる
・見えない場所にカビがありそうで不安
こうした不安を放置せず、調査や検査によって現状を正しく知ることが、問題解決への第一歩です。カビ問題は「気のせい」や「よくあること」で片づけてしまうと、住環境や健康面に長期的な影響を及ぼす可能性があります。
日本全国のカビトラブルに対応している**MIST工法®カビバスターズ**では、東京都足立区の住宅事情を踏まえたご相談も多く寄せられています。手に負えないカビ問題や、原因がわからず不安を感じている方こそ、専門的な視点を取り入れることで、状況を整理し、安心につなげることができます。
カビは早期発見・早期対応が何より重要です。
「まだ大丈夫」と思っている今こそ、一度立ち止まり、住まいの状態を見直してみてはいかがでしょうか。
カビ問題が心配な方へ|安心して暮らすために今できる正しい第一歩
「まだ大丈夫」が一番危険|不安を感じた時こそ室内環境を見直すタイミング
カビは、目に見えてから対処するものと思われがちですが、実際には**「心配だな」「何となくおかしい」と感じた時点が、最も大切なタイミング**です。東京都足立区で寄せられる相談の中にも、「もっと早く調べておけばよかった」という声は少なくありません。
特に現代の住宅は高気密・高断熱化が進み、外からは快適そうに見えても、内部では湿気や空気の流れに問題を抱えているケースがあります。そのため、カビが発生していても気づきにくく、知らないうちに室内環境が悪化していることもあります。カビ臭、結露の増加、家族の体調変化などは、住まいからの小さなサインかもしれません。
こうした不安を解消するために有効なのが、室内環境を客観的に確認するための検査や調査です。真菌検査によって空気中のカビ菌の状態を把握したり、建材の含水率や空気の流れを確認することで、「問題があるのか」「今後注意すべき点は何か」を整理することができます。これは、すでにカビが発生している場合だけでなく、将来のリスクを減らすための予防としても重要な考え方です。
カビ問題は、放置すればするほど判断が難しくなり、再発や悪化につながりやすくなります。逆に、早い段階で現状を知ることができれば、安心材料にもなり、無用な不安を抱え続ける必要もなくなります。
日本全国のカビトラブルに対応している**MIST工法®カビバスターズ**では、手に負えないカビ問題や原因がわからない不安に対し、調査・検査を重視した相談を受け付けています。
「これってカビ?」と感じたら、一人で悩まず、まずは住まいの状態を知ることから始めてみてください。それが、安心して暮らせる住環境への確かな一歩となります。
まとめ|東京都足立区のカビ問題は「正しく知ること」から始まります
調査・検査・原因理解が、再発しない安心な住環境づくりにつながる
東京都足立区で起こるカビ問題は、決して特別なケースではありません。高気密・高断熱化が進んだ現代住宅では、湿気や空気の流れ、結露などが複雑に絡み合い、誰の住まいでもカビが発生する可能性があります。だからこそ、「自分の家は大丈夫」と思い込まず、正しい知識を持つことが何より大切です。
本ブログでお伝えしてきたように、カビは目に見える場所だけの問題ではありません。壁の中、天井裏、床下といった見えない場所で進行し、気づいた時には室内環境全体に影響を及ぼしていることもあります。表面的な対処だけでは、再発を繰り返してしまう可能性が高いのが現実です。
そのため、カビ対策において重要なのは、
・なぜカビが発生したのか
・どこにリスクが潜んでいるのか
・今後注意すべき点は何か
これらを調査や検査によって正しく把握することです。真菌検査によるカビ菌の確認、建材の含水率測定、ファイバースコープを用いた内部調査、風量計による負圧確認などは、不安を「見える情報」に変えるための大切な手段です。
手に負えないカビトラブルや、原因がわからず不安を感じている方は、日本全国のカビ問題に対応している**MIST工法®カビバスターズ**へぜひご相談ください。
「カビがあるかどうか」だけでなく、「安心して暮らせる住環境かどうか」を判断することが、これからの住まい選び・住まい守りの新しい基準です。
不安を抱えたまま暮らすのではなく、正しく知り、正しく向き合う。
それが、東京都足立区で快適な住環境を守るための最も確実な方法と言えるでしょう。
------------------------------------------------------------------------------------------------------------------------
カビ取り・カビ対策専門業者MIST工法カビバスターズ本部
0120-052-127(平日9時から17時)
カビの救急箱
【検査機関】
一般社団法人微生物対策協会
------------------------------------------------------------------------------------------------------------------------